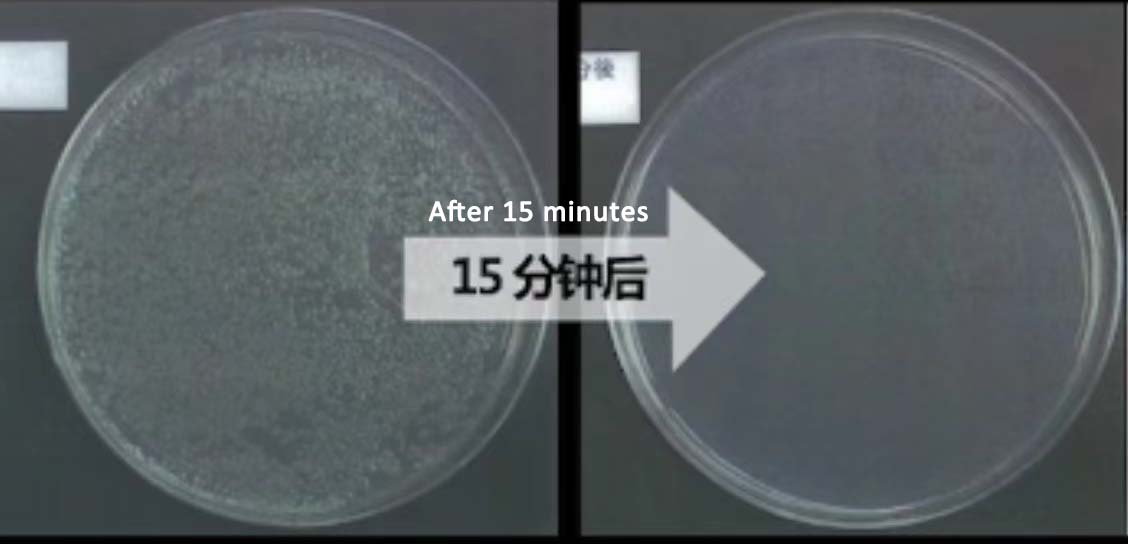
테스트 1.jpg

제품 설명
5% 나노실버 항균 세라믹 볼은 은 이온(Ag)의 제어된 방출을 통해 미생물 성장을 억제하도록 설계된 기능성 소재입니다.⁺). 이는 세라믹 구형체(일반적으로 알루미나나 규조토와 같은 다공성 재료로 만들어짐)에 중량 기준 5%의 나노 크기의 은 입자가 포함되어 있습니다.
제품 매개변수
제품 응용
(I) 수처리 및 환경보호
식수 정화
적용 시나리오: 가정용 정수기 필터 카트리지, 상업용 정수 장비, 야외 휴대용 정수 필터 등.
작용 기전: 나노실버 세라믹 볼은 물 속의 유기물을 흡수하고, 박테리아와 조류를 죽이고, 필터 카트리지 내 바이오필름 형성을 억제하며, 유출수의 품질을 개선합니다.
사례: 특정 브랜드의 정수기 필터 카트리지에 세라믹 볼을 추가한 후 총 콜로니 수를 10 CFU/mL 이하로 제어할 수 있습니다(국가 표준 한도는 100 CFU/mL).
하수 심층처리
적용 시나리오: 산업용 순환수 시스템, 양식업 폐수 처리, 병원 하수 소독 등
장점: 기존 염소 소독과 비교했을 때 나노실버 항균제는 잔류물이 없고 자극적인 냄새가 없어 물 속의 트리할로메탄(THM)과 같은 유해한 부산물의 위험을 줄일 수 있습니다.
(II) 의료 및 건강 분야
의료기기의 항균
적용 시나리오: 의료용 카테터(카테터, 정맥 주입 튜브 등), 내시경 액세서리, 치과 기구 등
효과: 물리적 접촉을 통해 박테리아 부착을 억제하면 카테터 관련 감염(CRBSI) 발생률을 30~50%까지 줄일 수 있습니다.
공중보건시설
적용 시나리오: 병원 병동 문 손잡이, 유치원 장난감 및 공중 화장실 난간과 같은 고주파 접촉 표면.
구현 방법: 세라믹 볼을 분쇄하여 항균 코팅을 만들거나 플라스틱이나 금속 기질에 삽입하여 지속적인 항균 보호 기능을 제공합니다.
(III) 가정 및 생활필수품
주방 및 욕실 제품
적용 분야: 설거지 스펀지, 도마, 변기 물탱크, 바닥 배수구 탈취 장치 등
사례: 특정 브랜드의 항균 도마에 나노실버 세라믹 볼 파우더를 첨가한 결과, 24시간 이내에 세균 증식이 90% 이상 감소했습니다.
섬유 및 웨어러블 기기
적용 시나리오: 스포츠웨어(양말, 속옷 등), 어린이 침구, 스마트 팔찌 스트랩 등.
공정: 세라믹 볼 미세분말을 방사 공정을 통해 폴리머 소재와 혼합하여 직물에 지속적인 항균 특성을 부여하는 동시에 통기성을 유지합니다.
(IV) 농업 및 식품 산업
식품접촉물질
적용 시나리오: 식품 가공 장비(컨베이어 벨트, 용기 등), 신선도 유지 포장재, 냉장 유통 운송 상자 등.
표준 준수: FDA, EU EC 1935/2004 및 기타 식품 접촉 물질 규정을 준수하며 살모넬라균, 리스테리아균과 같은 식품 매개 병원균을 억제할 수 있습니다.
양식 및 재배 산업
적용 시나리오: 어항 여과 시스템, 수경 식물 영양 용액 살균, 가축 및 가금류 식수 소독 등
장점: 기존의 화학 소독제(과망간산칼륨 등)를 대체하고 농장 유기체에 대한 약물 잔류물의 영향을 줄입니다.
회사 전시
Zhangqiu Longxin Corundum Products Co., Ltd.는 산둥성 지난시 장추구에 위치한 첨단 기술 환경 보호 회사입니다. 자세한 소개는 다음과 같습니다.회사는 1992년에 설립되었으며 원래 이름은 Zhangqiu Fuli Corundum Products Co., Ltd.입니다. 면적은 20,000평방미터가 넘습니다. 직원 수는 100~249명, 연간 수익은 100,001~500,000달러, 연간 수출률은 73%입니다. 정수 및 여과 재료의 연구 개발, 생산, 판매 및 서비스에 종사하고 있습니다. 주요 제품으로는 수소-물 재료, ORP 세라믹 볼, 미세 다공성 항균 세라믹 볼, MPH 알칼리 세라믹 볼, 마이판 세라믹 볼, 원적외선 세라믹 볼, 나노-은 항균 세라믹 볼, 염소-제거 세라믹 볼, 아황산칼슘 염소화 세라믹 볼, 토르말린 세라믹 볼, 자성 에너지 세라믹 볼 등이 있습니다. 이들 제품은 정수기, 기능성 수도꼭지, 스프링클러, 목욕, 건강 및 피트니스, 꽃과 식물 재배 등 수처리 산업, 공기 정화, 응축수 처리 산업에 널리 사용됩니다. 회사는 7개 이상의 특허를 보유하고 있으며 제품은 ISO 9001:2015, OHSAS 18001:2007 및 ISO 14001:2015 시리즈 시스템 인증을 통과했습니다. 회사는 일본, 한국, 말레이시아, 미국, 캐나다 및 이집트 등 전 세계에서 점점 더 많은 고객을 확보했습니다.